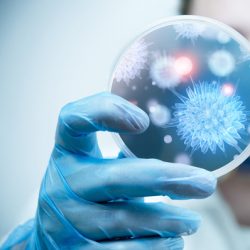

The International Agency for Research on Cancer (IARC), the cancer agency of the World Health Organization, has evaluated the carcinogenicity of the consumption of red meat and processed meat. Red meat After thoroughly reviewing the accumulated scientific literature, a Working Group of 22 experts from 10 countries convened by the IARC Monographs Programme classified the … [Read more...]
Cancer

Lung cancer specialist brings new treatments: A Mexican Study
This year, more than 158,000 Americans are expected to die from lung cancer. That's a staggering number: it's more than all the deaths expected from breast, prostate, colon, rectum, bladder and skin cancers combined. But this grim statistic only spurs Yanis Boumber, MD, PhD, to work harder toward a cure. Boumber, a lung cancer doctor and scientist, recently joined the … [Read more...]
Canine companionship helps calm children undergoing cancer treatment: A Study
Although survival rates for children diagnosed with cancer have increased dramatically over the past 40 years, hard evidence of proven psychosocial benefits to improve quality of life among patients and families during treatment has remained elusive. Many hospitals have therapy dogs who visit with patients, and anecdotal evidence underscores the positive impact these … [Read more...]
Cancer survivors often have poor diets: A Study
While most cancer survivors in the United States are motivated to seek information about food choices and dietary changes to improve their health, a new study comparing their dietary patterns to federal guidelines indicates that they often fall short. Published early online in CANCER, a peer-reviewed journal of the American Cancer Society, the findings point to the need for … [Read more...]
Later age recommended for first screening mammogram is now 45: American Cancer Society Study
Among the changes in the American Cancer Society's updated breast cancer screening guideline is that women with an average risk of breast cancer should undergo regular, annual screening mammography beginning at age 45 years, with women having an opportunity to choose to begin annual screening as early as age 40; women 55 years and older should transition to screening every … [Read more...]
Vitamin D and calcium supplements fail to protect against colorectal cancer: A Study
A large, randomized study at 11 U.S. hospitals including Dartmouth-Hitchcock Medical Center found that vitamin D and calcium supplements fail to protect against developing colorectal cancer. The study results, published in the New England Journal of Medicine, did not support earlier observational studies suggesting a link between lower colorectal cancer risk with higher … [Read more...]
Orange lichens are potential source for anticancer drugs: A Study
An orange pigment found in lichens and rhubarb called parietin may have potential as an anti-cancer drug, scientists at Winship Cancer Institute of Emory University have discovered. The results are scheduled for publication on October 19 in Nature Cell Biology. Parietin, also known as physcion, could slow the growth of and kill human leukemia cells obtained directly from … [Read more...]
Telomerase enzyme play a significant role in aging and cancer: University of California Study
An enzyme called telomerase plays a significant role in aging and most cancers, but until recently many aspects of the enzyme's structure could not be clearly seen. Now, scientists from UCLA and UC Berkeley have produced images of telomerase in much higher resolution than ever before, giving them major new insights about the enzyme. Their findings, published online today by … [Read more...]
Nutrients turn on key tumor signaling molecule, fueling resistance to cancer therapy: University of California Study
Tumors can leverage glucose and another nutrient, acetate, to resist targeted therapies directed at specific cellular molecules, according to Ludwig Cancer Research scientists studying glioblastoma, a deadly brain cancer. The findings, published in the July 13 Proceedings of the National Academy of Sciences, demonstrate that nutrients can strongly affect the signaling … [Read more...]
Cancer discovery links experimental vaccine and biological treatment: University of Wisconsin-Madison Study
A new study at the University of Wisconsin-Madison has linked two seemingly unrelated cancer treatments that are both now being tested in clinical trials. One treatment is a vaccine that targets a structure on the outside of cancer cells, while the other is an altered enzyme that breaks apart RNA and causes the cell to commit suicide. The study was published July 13 in the new … [Read more...]
Women: A longer break from work leads to less interest in a career: A German Study
Family policy influences not only families’ economic behaviour, but also sends out clear normative signals on which people base their individual life plans: The longer a mother takes a break from work after the birth of a child, the more she loses interest in her own career: Professor Markus Gangl and Dr. Andrea Ziefle, sociologists at Goethe University in Frankfurt, are now … [Read more...]
New treatment for bladder cancer: A Spanish Study
Universitat Autònoma de Barcelona researchers have found a mycobacterium that is more effective in treating superficial bladder cancer and does not cause infections, unlike those used up to now. Mycobacteria are the only bacteria used in cancer treatment. The administration of the bacterium Mycobacterium bovis (BCG), is the current treatment for superficial bladder cancer. … [Read more...]
Sniffing out cancer with improved ‘electronic nose’ sensors
Scientists have been exploring new ways to "smell" signs of cancer by analyzing what's in patients' breath. In ACS' journal Nano Letters, one team now reports new progress toward this goal. The researchers have developed a small array of flexible sensors, which accurately detect compounds in breath samples that are specific to ovarian cancer. Diagnosing cancer … [Read more...]
Esophageal Cancer: Killing a Silent Killer
This year alone, 17,000 Americans will be diagnosed with esophageal cancer and 16,000 of them will die from it. People who have Barrett’s esophagus, a condition where normal tissue in the esophagus changes due to acid reflux, are at the highest risk of getting the disease. Now, there is more information on treatment options for those with this difficult disease. Seventy-two … [Read more...]
Spiritual beliefs relate to cancer patients’ physical, mental, and social well-being: A Study
Research reveals that most individuals with cancer have religious and spiritual beliefs, or derive comfort from religious and spiritual experiences. But what impact does this have on patients' health? Recent analyses of all published studies on the topic--which included more than 44,000 patients--shed new light on the associations of religion and spirituality with cancer … [Read more...]
Risk factors for prostate cancer: A Study
New research suggests that age, race and family history are the biggest risk factors for a man to develop prostate cancer, although high blood pressure, high cholesterol, vitamin D deficiency, inflammation of prostate, and vasectomy also add to the risk. In contrast, obesity, alcohol abuse, and smoking show a negative association with the disease. Details are reported in the … [Read more...]
New drug for kidney cancer: A Study
A new drug has been found superior to current treatments in slowing the growth of advanced kidney cancer in patients who became resistant to the first-line therapies that had kept it in check, according to results from a clinical trial led by Dana-Farber Cancer Institute. Such patients are currently treated with everolimus (Affinitor), a second-line therapy, which can halt … [Read more...]
Fungi may lead to cheaper cancer treatment: University of Guelph Study
Cheaper anti-cancer drugs for humans might ultimately stem from a new study by University of Guelph scientists into a kind of microbial "bandage" that protects yew trees from disease-causing fungi. A new paper published in Current Biology is the first to show how beneficial fungi living naturally in yew trees serve as a combination bandage-immune system for the plant, says … [Read more...]
Dried plums can reduce risk of colon cancer: A Study
Researchers from Texas A&M University and the University of North Carolina have shown a diet containing dried plums can positively affect microbiota, also referred to as gut bacteria, throughout the colon, helping reduce the risk of colon cancer. The research was funded by the California Dried Plum Board and presented at the 2015 Experimental Biology conference in … [Read more...]
Moderate drinking linked to increased risk of some cancers in women: A Study
Even light and moderate drinking (up to one drink a day for women and up to two drinks a day for men) is associated with an increased risk of certain alcohol related cancers in women and male smokers, suggests a large study published by The BMJ today. Overall, light to moderate drinking was associated with minimally increased risk of total cancer in both men and … [Read more...]
Promising drugs for cancer: A Cancer Research UK Study
Cancer Research UK scientists have shown that a class of experimental drug treatments already in clinical trials could also help the body's immune system to fight cancer, according to a study published in the journal Cell. Scientists at the University of Edinburgh revealed that a protein called Focal Adhesion Kinase, or FAK -- which is often overproduced in tumours -- … [Read more...]
Titanium, gold based compound fights kidney cancer: University of Hawaii Study
Researchers developed a promising metal-based compound that destroys kidney cancer cells, while leaving normal cells unharmed. The findings may provide a new way of treating kidney cancer, opening the potential for more potent and less toxic therapies that would give cancer patients a better quality of life. "Kidney cancer is frequently diagnosed in the late stages when … [Read more...]
Two-drug combination shows promise against one type of pancreatic cancer: University of Florida Study
One form of pancreatic cancer has a new enemy: a two-drug combination discovered by UF Health researchers that inhibits tumors and kills cancer cells in mouse models. For the first time, researchers have shown that a certain protein becomes overabundant in pancreatic neuroendocrine tumors, allowing them to thrive. They also found that pairing a synthetic compound with an … [Read more...]
New drugs could stop growth of drug-resistant childhood tumors: A Study
Current drugs may stop working against the most common type of brain tumor in children, medulloblastoma, but the tumor could be targeted in a new way, according to Stanford University scientists. In research to be published in the journal eLife, a team led by Prof. Matthew P. Scott at the University's School of Medicine tested a drug called Roflumilast in mice with a brain … [Read more...]
LAM Lung Disease
Women in their childbearing years are the targets of a rare lung disease most of us have never even heard of called LAM — now, for the first time ever, patients have an approved treatment to keep them on their feet. There’s very little that can slow Alison Hedervary these days, but for years, she would get short of breath with any activity. Doctors weren’t concerned until … [Read more...]
Findings could shed light on cancer and aging: A Johns Hopkins University Study
Researchers at the Johns Hopkins University have found molecular evidence of how a biochemical process controls the lengths of protective chromosome tips, a potentially significant step in ultimately understanding cancer growth and aging. In a paper recently published as the cover story in the online journal eLife, biologist David C. Zappulla and graduate student Evan P. … [Read more...]
New risk score for colorectal cancer could guide selection of screening tests: Indiana University School of Medicine Study
Researchers at the Regenstrief Institute and the Indiana University School of Medicine have developed a new risk assessment scoring system that could help physicians judge which patients can forgo invasive colonoscopy testing for cancer screening and which should receive the test. According to published literature and guideline organizations, 85 percent of the population is … [Read more...]
Examination of use of diabetes drug pioglitazone and risk of bladder cancer: A Study
Although some previous studies have suggested an increased risk of bladder cancer with use of the diabetes drug pioglitazone, analyses that included nearly 200,000 patients found no statistically significant increased risk, however a small increased risk could not be excluded, according to a study in the July 21 issue of JAMA. Assiamira Ferrara, M.D., Ph.D., of Kaiser … [Read more...]
Aspirin could hold key to supercharged cancer immunotherapy: A Study
Giving cancer patients aspirin at the same time as immunotherapy could dramatically boost the effectiveness of the treatment, according to new research published in the journal Cell. Francis Crick Institute researchers, funded by Cancer Research UK, have shown that skin, breast and bowel cancer cells often produce large amounts of prostaglandin E2 (PGE2). This molecule … [Read more...]
Lung cancer patients who stop smoking live longer: A Study
Tobacco cessation provided significant survival benefit for lung cancer patients who quit smoking shortly before or after diagnosis, despite the severity of the disease. Results of the Roswell Park Cancer Institute study were published in the Journal of Thoracic Oncology. Roswell Park has a unique Tobacco Assessment and Cessation Service (TACS) that conducts a standardized … [Read more...]
- « Previous Page
- 1
- …
- 6
- 7
- 8
- 9
- 10
- …
- 38
- Next Page »